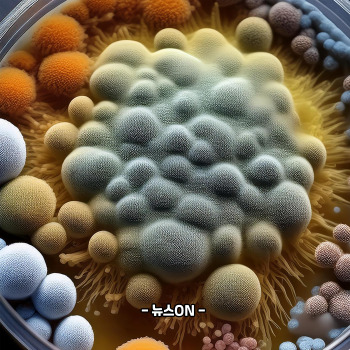
김치 곰팡이

김치 곰팡이 | 김치 흰색곰팡이 왜 생기나
김치 곰팡이 섭취
며칠 전 김치통을 열었는데 표면에 하얀 막이 둥둥 떠 있어서 깜짝 놀랐습니다. 김장철이 다가오니 김치 보관에 더 신경 쓰고 있었는데도 이런 모습을 보니 ‘이거 먹어도 되나?’ 하는 걱정이 먼저 들었어요. 저처럼 김치에서 보이는 하얀막이 곰팡이인지, 발효 과정인지 헷갈리는 분들이 참 많습니다.
그래서 이번 글에서는 김치 하얀곰팡이(백막)의 정체, 왜 생기는지, 먹어도 되는지, 진짜로 위험한 곰팡이는 무엇인지, 그리고 절대 먹으면 안 되는 경우까지 한 번에 정리해 드립니다.습니다.
1) 김치 하얀곰팡이의 정체 — 대부분은 곰팡이가 아닌 ‘백막(효모)’

김치 표면에 얇고 하얀막처럼 보이는 것은 대부분 곰팡이가 아니라 효모(백막)입니다. 이는 김치가 발효되는 과정에서 자연스럽게 생기는 미생물로, 산소에 노출된 표면에 주로 나타납니다.
소금 농도, 온도, 보관 기간, 김치 양의 감소로 인해 발효환경이 흔들리면 백막 생성이 더 쉬워지고, 김치국물로 충분히 덮이지 않은 표면에서 자주 발생합니다. 백막은 독성이 없고 발효식품에서도 흔하게 나타나기 때문에 걷어내고 먹을 수 있는 경우가 많습니다.
2) 하얀막(백막)과 진짜 곰팡이의 구분법




백막은 얇고 매끈하며 긁으면 미끄럽게 떨어지는 특징을 가지고 있습니다. 표면에만 존재하며 김치 내부까지 침투하지 않는다는 점도 중요한 차이입니다. 반면 곰팡이는 솜털처럼 부풀고, 색이 다양하며(초록·파란·검정·회색), 얼룩처럼 번져가고 김치 속까지 뿌리를 내립니다.
형태로도 차이를 쉽게 볼 수 있는데, 백막은 막처럼 평평하게 떠 있는 반면 곰팡이는 군락을 이루며 번지고 입체적으로 솟아오르는 모습이 보입니다. 냄새도 구분 요소가 되는데, 백막은 김치 냄새와 비슷하지만 곰팡이는 쿰쿰하거나 먼지 냄새 같은 곰팡내가 납니다.
3) 김치 곰팡이를 먹어도 되는지 — 백막은 가능, 곰팡이는 절대 불가
하얀 백막은 걷어내고 먹을 수 있지만, 색이 있는 실제 곰팡이는 절대 섭취하면 안 됩니다. 곰팡이가 생성하는 독성 물질 ‘마이코톡신’은 냉장고 온도에서도 파괴되지 않고, 눈에 보이는 범위보다 훨씬 넓게 퍼지는 특징이 있습니다.
특히 검은색·초록색·파란색·분홍색 계열의 곰팡이는 독성이 강해 면역력이 약한 노인·어린이·임산부에게 더 위험할 수 있습니다. 김치는 국물과 줄기·잎 결 사이로 균이 깊이 스며드는 구조라 겉만 제거하고 먹는 방식은 절대 안전하지 않습니다.
4) 김치 하얀곰팡이(백막)가 생기는 이유




김치통을 자주 열어 산소가 반복적으로 들어가면 백막이 쉽게 생기며, 냉장 온도가 높거나(2도 이상) 김치 표면이 양념이나 국물로 덮여 있지 않을 때 발생 확률이 높아집니다. 김치가 줄어들며 위쪽 공간이 비게 되면 공기 접촉면이 넓어져 백막이 생길 조건이 더 좋아집니다.
이처럼 백막은 부패의 신호가 아니라 발효 과정의 흔한 현상이며, 번거롭지만 걷어내고 관리하면 크게 문제되지 않는 미생물입니다.
5) 김치에 곰팡이가 생겼을 때 대처법
백막은 걷어낸 뒤 김치국물을 위까지 붓고 공기 노출을 줄이면 되고, 통 크기를 줄이는 것도 좋은 방법입니다. 반면 색이 있는 곰팡이는 전체 폐기가 원칙입니다. 김치가 층층이 구성된 식품이라는 점 때문에 독소가 어디까지 스며들었는지 알 수 없고, 일부만 버리는 방식은 위험합니다.
특히 김치속 잎이나 줄기 사이에 곰팡이가 들어갔다면 이미 빠르게 퍼진 상태로 보고 전체를 버려야 안전합니다.
6) 김치 곰팡이 예방 방법




김치 표면이 항상 국물이나 양념으로 덮여 있도록 관리하는 것이 가장 중요합니다. 김치를 덜 때는 젓가락·숟가락에 물기가 묻지 않도록 하고, 통을 자주 열지 않도록 주의해야 합니다. 냉장고 온도는 0~2도를 유지하는 것이 가장 좋고, 통을 꽉 채워 빈 공간을 최소화하면 공기 접촉을 크게 줄일 수 있습니다.
7) 절대 먹으면 안 되는 김치 곰팡이
1) 색이 선명하게 보이는 곰팡이 — 초록·검정·파란·분홍 계열 모두 폐기
다음 특징이 보이면 이미 곰팡이가 김치 속 깊숙이 퍼진 상태입니다.
• 초록·검정·파란·분홍처럼 색이 또렷함
• 얼룩이 점점 퍼지는 형태
• 표면이 솜털처럼 일어남
• 작은 점이 군락 형태로 번져감
• 톡 쏘는 흙냄새·먼지 냄새가 느껴짐
이런 곰팡이는 마이코톡신 생성 가능성이 매우 높아 겉만 제거해도 안전하지 않으며, 내부 조직까지 오염된 것으로 보고 즉시 전량 폐기해야 합니다.
2) 김치 줄기·잎 사이 깊숙이 침투한 곰팡이 — 부분 제거 금지
다음 특징이 보이면 위험합니다.
• 김치 잎 사이에 곰팡이 실처럼 보임
• 줄기 깊은 곳까지 점이 박혀 있음
• 국물 속에 곰팡이 부스러기가 떠다님
• 김치 전체에서 곰팡내가 풍김
김치는 층 구조이기 때문에 곰팡이가 내부까지 얼마나 퍼졌는지 육안으로 확인하기 어렵습니다. 일부만 버리고 먹는 방식은 매우 위험하며 반드시 전체를 버려야 합니다.
3) 냄새로 먼저 감지되는 곰팡이 — 색이 없어도 전량 폐기
다음 특징이 보이면 색이 없어도 이미 퍼진 상태입니다.
• 미세한 곰팡내
• 젖은 먼지 냄새
• 발효 냄새와는 다른 쿰쿰함
• 김치 전체에서 냄새가 퍼짐
육안으로 보이지 않아도 이러한 냄새는 곰팡이가 이미 대량 번식했음을 의미합니다. 독소 생성 가능성이 높아 즉시 폐기해야 합니다.
모든게 나쁜 곰팡이는 아니에요! 효모와 구분해서 먹어야해요.
김치를 열었을 때 보이는 하얀막이 전부 곰팡이는 아니지만, 색이 있는 곰팡이나 냄새가 나는 경우는 절대 섭취해서는 안 됩니다. 백막은 발효 과정에서 자연스럽게 생기는 경우가 많지만, 색깔 곰팡이는 독소를 만들 수 있어 전체 폐기가 원칙입니다. 김치가 공기에 닿지 않도록 관리하고 냉장 온도를 일정하게 유지하는 것만으로도 곰팡이를 크게 줄일 수 있으니, 김장철일수록 조금 더 꼼꼼하게 보관해보시면 좋겠습니다.
2025.11.21 - [건강] - 물김치 맛있게 담그는법 | 물김치 황금레시피 | 물김치 국물 맛있게 하는 방법
물김치 맛있게 담그는법 | 물김치 황금레시피 | 물김치 국물 맛있게 하는 방법
물김치 맛있게 담그는법 | 물김치 황금레시피 물김치 국물 맛있게 하는 방법 요즘처럼 입맛이 쉽게 무뎌지는 계절에는 깔끔하게 넘어가고 시원하게 마실 수 있는 물김치가 참 잘 어울립니다. 저
fastupdatenews1.com
2025.11.06 - [건강] - 김장김치 보관하는 방법 | 김장김치 비닐보관 | 보관 온도 냉장 냉동
김장김치 보관하는 방법 | 김장김치 비닐보관 | 보관 온도 냉장 냉동
🥬 김장김치 보관하는 방법 | 김장김치 비닐보관 김장김치 보관 온도 🥬 겨울의 시작은 김장에서부터입니다. 새하얀 배추 속이 붉은 양념에 물들기 시작하면, 집안 공기는 유난히 따뜻해지고,
fastupdatenews1.com
2025.11.01 - [건강] - 김장김치 양념 황금레시피 | 김장김치 20kg 양념 비율 | 김장김치 육수 만드는 법
김장김치 양념 황금레시피 | 김장김치 20kg 양념 비율 | 김장김치 육수 만드는 법
🥬 김장김치 양념 황금레시피 김장김치 20kg 양념 비율 | 김장김치 육수 만드는 법 어릴 적 겨울이면 집 안 가득 고춧가루와 새우젓 냄새가 퍼지던 기억이 납니다. 마당엔 소금물에 절인 배추가
fastupdatenews1.com
2025.11.17 - [건강] - 배추겉절이 만드는법 | 배추겉절이 황금레시피 | 재료
배추겉절이 만드는법 | 배추겉절이 황금레시피 | 재료
배추겉절이 만드는법 | 배추겉절이 황금레시피겨울이 가까워지면 배추의 단단한 결이 살아나고 단맛이 깊어져, 겉절이 한 그릇만 있어도 밥상 분위기가 달라집니다. 어렵지 않은 반찬이지만 배
fastupdatenews1.com
2025.11.13 - [건강] - 파김치 맛있게 담그는법 | 파김치 황금 레시피 | 파김치 양념 재료
파김치 맛있게 담그는법 | 파김치 황금 레시피 | 파김치 양념 재료
파김치 맛있게 담그는법 | 파김치 황금 레시피 파김치 양념 김장철이 다가오면 집 안에 고춧가루 향이 은근히 퍼지고, 부엌 한쪽에서는 쪽파 한 단이 정갈하게 다듬어집니다. 그 계절의 냄새, 그
fastupdatenews1.com
'건강' 카테고리의 다른 글
| 김장김치 빨리 익히는 방법 (0) | 2025.11.23 |
|---|---|
| 이 증상 보이면 심부전 초기일 수 있습니다 놓치기 쉬운 심부전 초기증상 7가지 (0) | 2025.11.23 |
| a형 독감 증상 | a형 독감 잠복기 | 전염 | 치료 (0) | 2025.11.21 |
| 비타민B1 효능 | 티아민 효능 | 비타민B1 이란 : 피로회복 숙취 손발저림 (0) | 2025.11.21 |
| 물김치 맛있게 담그는법 | 물김치 황금레시피 | 물김치 국물 맛있게 하는 방법 (0) | 2025.11.21 |